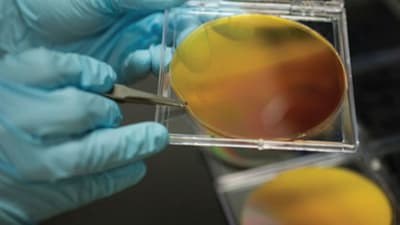
Feature Image

8,33,42,44,45,47,52,54,68
61
169
-1
1740
30
Briefs: Electronics & Computers
Integrated Three-Dimensional Module Heat Exchanger for Power Electronics Cooling
Critical elements in the operation of electric drive systems are power electronics and power semiconductor packages. Improving thermal management of power electronics can help reduce the cost, weight, and volume of electric drive systems, and thus increase market...
Briefs: Software
ScienceOrganizer: A Scientific Knowledge Management and Remote Experimentation Tool
The ScienceOrganizer system was designed to facilitate the work of geographically distributed NASA science teams by supporting the organization, administration, documentation, and execution of science projects and missions. The capabilities of ScienceOrganizer...
Briefs: Electronics & Computers
A method was created for electroless deposition of conformal ultrathin (<20 nm) metal oxides on the high-surface-area walls of commercial carbon nanofoam papers, typically 0.1–0.3 mm thick. The resulting...
Briefs: Software
Knowledge Preservation Management
The Knowledge Preservation Management (KPM) system allows for the capture, management, and Web-based access of manufacturing operations information. KPM also captures retirees' knowledge via transcript-enabled video-taped interviews, and with video data-mining advanced search capabilities. Access to this...
Briefs: Electronics & Computers
Interest in wearable electronics for continuous, long-term health and performance monitoring is rapidly increasing. The reduction in power levels consumed by sensors and electronic...
Briefs: Software
Development of Automated Structural Health Monitoring for Composite Overwrapped Pressure Vessels
Virtually all NASA spacecraft use composite overwrapped pressure vessels (COPVs) to reduce the weight disadvantage of metal pressure vessels. However, these composite structures are more susceptible to damage than metal PVs, are difficult to inspect,...
Briefs: Software
System breakdowns in modern industrial environments can result in millions of dollars in lost time and productivity, and even the loss of life and property. In the utilities industry — where the continuous...
Briefs: Software
Robust Mesh Update Method for Grid Motion Problems
Over the past several decades, one class of problems in computational fluid dynamics (CFD) that has undergone substantial development involves movement of the fluid domain boundary. The problem class exists when the fluid domain boundary is either explicitly time-dependent, or is known a priori and...
Briefs: Aerospace
An Upwind Parabolized Navier-Stokes Solver (UPS) for Supersonic and Hypersonic Flow Simulation, Version 6.1
The simulation of high-speed flow involves unique challenges such as the treatment of strong flow gradients associated with shock waves and expansion fans, as well as the modeling, at hypersonic speeds, of air chemistry effects. However,...
Briefs: Software
Efficient Two-Dimensional Solution Methods for the Navier-Stokes Equations
ARC2D is a computational fluid dynamics (CFD) program for two-dimensional airfoil and simply connected geometries. The program uses implicit finite-difference techniques to solve two-dimensional Euler equations and Navier-Stokes equations. It is based on the Beam and Warning...
Briefs: Software
Using SysML to Model Layered System Interfaces
To produce accurate system architecture descriptions, it is essential to be able to describe interfaces between system elements at different levels of abstraction and from different perspectives at the same time. For example, the connection from system A to system B may be viewed at a high level as...
Briefs: Software
Pegasus 5.2 Software for Automated Pre-Processing of Overset CFD Grids
Pegasus software is used as a pre-processor for overset-grid Computational Fluid Dynamics (CFD) simulations. It provides the hole-cutting and connectivity information between structured overset grids. The main features of the software include automated hole-cutting algorithms, a...
Briefs: Software
Software Suite for Identifying Suspicious Individuals
It can be very useful to know about activities among individuals; for example, which individuals are associated with other individuals? When two or more individuals get together, is there an intended purpose? Who are the leaders or important individuals of a group? What is the organizational...
Briefs: Electronics & Computers
Printed electronics must be heated to melt all the nanoparticles together into a single conductive wire, making it impossible to print circuits on inexpensive plastics or paper. A study...
Briefs: Software
The Automated Impacts Routing (AIR) software is advanced route finding technology for air and ground vehicles. The software provides users the ability to find optimized paths through airspace...
Briefs: Software
Automated Transfer Function Generator
When designing or analyzing electrical systems, it is important to understand the relationship between input and output. Power conversion occurs in a “black box,” and transfer functions can be used to provide a better understanding of the processes occurring in this black box. Although they provide a useful...
Briefs: Electronics & Computers
Electrically Conducting Nanoscale Sheets for Reconfigurable Electronics
Almost all aspects of modern life, such as communications and healthcare, depend on microelectronic devices. The demand for more powerful, smaller technology keeps growing, meaning that the tiniest devices are now composed of just a few atoms. One way to solve the problem of...
Briefs: Software
Python Interface to Dual-Pol Radar Algorithms (DualPol)
This object-oriented Python module facilitates precipitation retrievals (e.g., hydrometeor type, precipitation rate, precipitation mass, particle size distribution) from polarimetric radar data. It leverages existing open-source radar software packages to perform all-in-one retrievals that are...
Briefs: Software
Sound Lab (SLAB) Version 5
Interest in the simulation of acoustic environments has prompted a number of technology development efforts over the years for applications such as auralization of concert halls and listening rooms, spatial information displays in aviation, virtual reality, and better sound effects for video games. Each of these...
Briefs: Energy
Solar fuels are created using only sunlight, water, and carbon dioxide (CO2). Researchers are exploring a range of target fuels, from hydrogen gas to liquid hydrocarbons, but producing any of these...
Briefs: Software
CornerStone Knowledge Acquisition and Synthesis Framework
In general, and especially in the “big data” era, there is often a failure to collect sufficient data about the data (metadata). This lack of metadata drastically reduces the potential use of the data, and the attempt to rectify this situation after the fact is often difficult, if not...
Briefs: Software
Graph analytics is a way of facilitating guided graph exploration through visual and interactive means. Unlike many graph visualization research efforts that focus predominantly on layout algorithms and rendering...
Briefs: Electronics & Computers
Fields ranging from autonomous driving to personalized medicine are generating huge amounts of data. But just as the flood of data is reaching massive proportions, the ability of computer chips to...
Briefs: Electronics & Computers
Front-end electronics for capacitive sensors typically include a preamplifier followed by a filter. The preamplifier provides low-noise amplification of the signals induced in the sensor electrodes....
Briefs: Software
Software-Defined Networking (SDN) usually requires network administrators to be skilled in programming languages such as C++, Python, or Ruby. Many IT operators tasked with...
Briefs: Software
Robust Method for Data Protection and Change Detection
Methods exist for processing an original data sequence in order to generate information about the data for the purposes of integrity measurement, ownership demonstration, and authentication. The first category is digital watermarking, the second is data hashing, and the third is error detection...
Briefs: Software
High-Speed Network Protocol for Faster, More Reliable Emergency Response
Anew network protocol — the Multi Node Label Routing (MNLR) protocol — was developed to improve the information flow between emergency responders at the scene of an incident and decision-makers at the office of emergency management.
Briefs: Electronics & Computers
A voltage detector chip was developed that requires only a few trillionths of a Watt (picowatts) to activate other circuits, enabling engineers to design sensors that continuously listen, without...
Briefs: Software
Custom Administration Reporting (gTracker)
A reporting tool was needed that could indicate the accuracy of search results by tracking the number of clicks required by users to find their desired search results. The application should also capture the number of times other links and like filtering components are clicked. The report should have the...
Top Stories
Blog: Lighting
A Stretchable OLED that Can Maintain Most of Its Luminescence
Blog: Energy
Batteries that Can Withstand the Cold
INSIDER: Energy
Advancing All-Solid-State Batteries
Blog: Power
My Opinion: We Need More Power Soon — Is Nuclear the Answer?
Quiz: Power
Blog: Data Acquisition
Webcasts
 Upcoming Webinars: Test & Measurement
Upcoming Webinars: Test & Measurement
From Spreadsheets to Insights: Fast Data Analysis Without Complex...
 Upcoming Webinars: Defense
Upcoming Webinars: Defense
Cooling a New Generation of Aerospace and Defense Embedded...
 Upcoming Webinars: AR/AI
Upcoming Webinars: AR/AI
Beyond AI-Copy-Paste Engineering: Advanced AI-Integration Success...
 Upcoming Webinars: Automotive
Upcoming Webinars: Automotive
Battery Abuse Testing: Pushing to Failure
 Upcoming Webinars: Connectivity
Upcoming Webinars: Connectivity
A FREE Two-Day Event Dedicated to Connected Mobility
 Upcoming Webinars: RF & Microwave Electronics
Upcoming Webinars: RF & Microwave Electronics
Choosing the Right N-Port Strategy: Multiport VNAs vs. Switch...